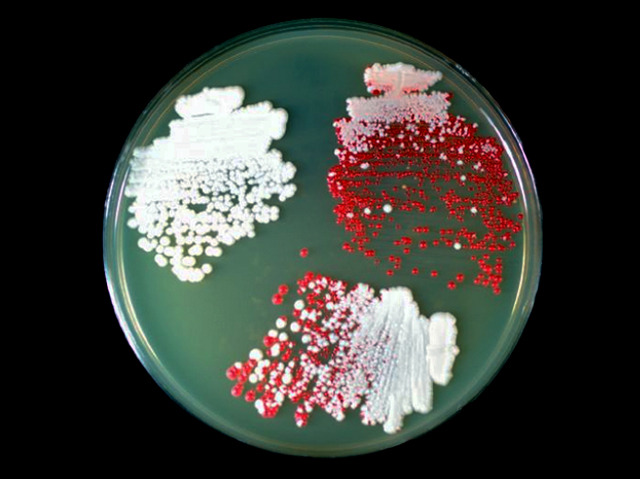

27 July 2014
Kettling Proteins
Prions are infectious proteins that can cause deadly diseases like bovine spongiform encephalopathy, or mad cow disease. They also infect yeast cells and this simple fungus has been found to produce a protein, Btn2, that targets prions and kettles them into a small area inside the cell, rather like the way riot police control an unruly crowd. When the cell divides, one of the two offspring is free from prions and can thrive. Intriguingly, Btn2 has similarities to human hook proteins, which play an important role in positioning components inside human cells so they can divide correctly. Pictured are three yeast colonies, the top right producing Btn2 and with mainly healthy cells (stained red) and some infected by prions (white). The lower colony is producing Cur1, a protein allied to Btn2 and has some healthy cells, while the top left colony is producing neither protein and is heavily infected.
Written by
Search The Archive
Submit An Image
Like us on Facebook
Follow on Twitter
Follow on Tumblr
Follow on Instagram
What is BPoD?
BPoD stands for Biomedical Picture of the Day. Managed by the MRC Laboratory of Medical Sciences until Jul 2023, it is now run independently by a dedicated team of scientists and writers. The website aims to engage everyone, young and old, in the wonders of biology, and its influence on medicine. The ever-growing archive of more than 4000 research images documents over a decade of progress. Explore the collection and see what you discover. Images are kindly provided for inclusion on this website through the generosity of scientists across the globe.
BPoD is also available in Catalan at www.bpod.cat with translations by the University of Valencia.








